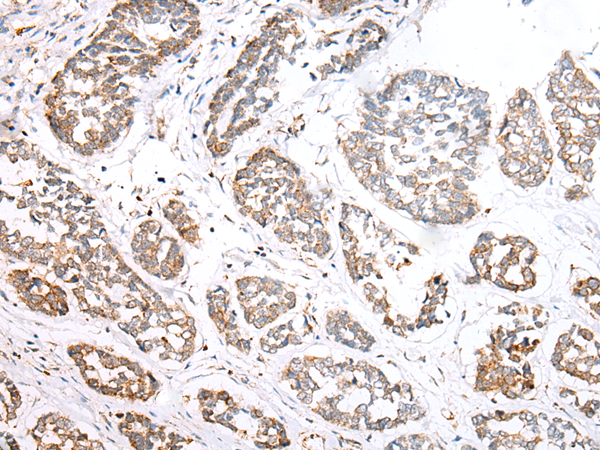

中文名稱: 兔抗NLRP1多克隆抗體
英文名稱: Anti-NLRP1 rabbit polyclonal antibody
別 名: NAC; CARD7; CIDED; NALP1; SLEV1; DEFCAP; PP1044; VAMAS1; CLR17.1; DEFCAP-L/S
相關類別: 一抗
儲 存: 冷凍(-20℃)
宿 主: Rabbit
抗 原: NLRP1
反應種屬: Human
標 記 物: Unconjugate
克隆類型: rabbit polyclonal
技術規格
|
Background: |
This gene encodes a member of the Ced-4 family of apoptosis proteins. Ced-family members contain a caspase recruitment domain (CARD) and are known to be key mediators of programmed cell death. The encoded protein contains a distinct N-terminal pyrin-like motif, which is possibly involved in protein-protein interactions. This protein interacts strongly with caspase 2 and weakly with caspase 9. Overexpression of this gene was demonstrated to induce apoptosis in cells. Multiple alternatively spliced transcript variants encoding distinct isoforms have been found for this gene, but the biological validity of some variants has not been determined. |
|
Applications: |
ELISA, IHC |
|
Name of antibody: |
NLRP1 |
|
Immunogen: |
Synthetic peptide of human NLRP1 |
|
Full name: |
NLR family, pyrin domain containing 1 |
|
Synonyms: |
NAC; CARD7; CIDED; NALP1; SLEV1; DEFCAP; PP1044; VAMAS1; CLR17.1; DEFCAP-L/S |
|
SwissProt: |
Q9C000 |
|
ELISA Recommended dilution: |
1000-2000 |
|
IHC positive control: |
Human esophagus cancer |
|
IHC Recommend dilution: |
10-50 |
購物車
幫助
021-54845833/15800441009
